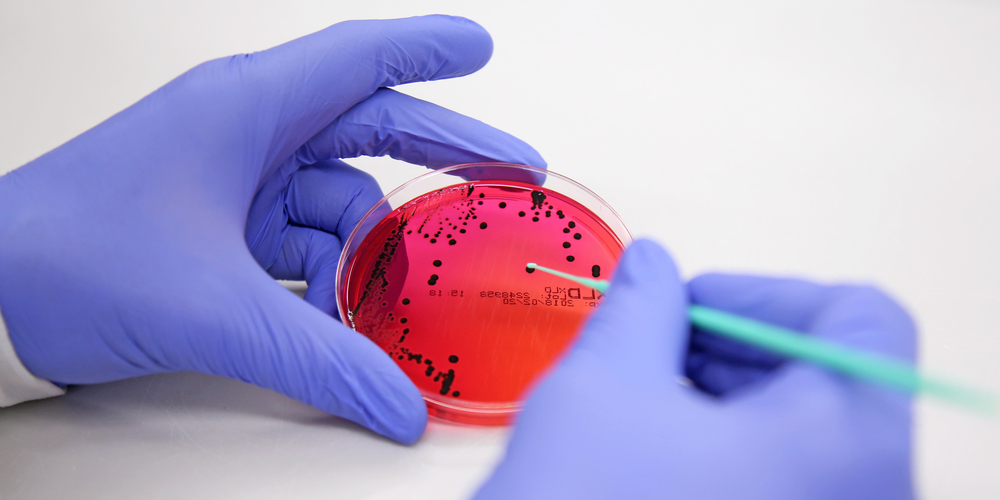

Mittagspause in Sicht! Es ist heiss, man hat Lust auf etwas Leichtes und möchte im kühlen Büro bleiben. Sushi bestellen wäre etwas. Aber roher Fisch, der durch die Hitze transportiert wird? Lebensmittelhygiene ist besonders im Sommer ein Thema. Da mag wohl mancher und manche lieber bei der bewährten Pizza bleiben, die aus dem glutheissen Ofen gezogen wird und im Büro dann vielleicht etwas pampig, aber sicher nicht verdorben ankommt.
In den Zeiten der Pandemie flitzten unzählige Essenskuriere in allen Farben kreuz und quer durch die Stadt. Dabei hatten die «Food Delivery Services», wie man im weltläufigen Zürich gerne sagt, schon vor Corona deutlich Fahrt aufgenommen. Während der Pandemie suchten aber auch viele Restaurants ihr Heil im Liefern von Essen – eine ganze Branche musste umdenken und neue Vertriebskanäle aufbauen. Dass da nicht immer ganz alles ordnungsgemäss und sachgerecht ablief, kann man sich leicht vorstellen. Nun hat das Kantonale Labor Zürich (KLZH) in seinem Jahresbericht 2021 das Thema Hygiene bei Lebensmitteltransporten aufgegriffen und überraschende Zusammenhänge zur Sprache gebracht.
Ein wenig «zu kreativ»
Im Editorial des Berichts steht, dass ein bedeutender Teil der während der Pandemie eröffneten Vertriebswege wohl weiter erhalten bleibe. Und dann heisst es klipp und klar: «Die Instrumente der Lebensmittelkontrolle konnten bei dieser Entwicklung allerdings nicht mithalten.» Heisst das nun, dass der Kanton sich ausserstande sieht, die nötigen Kontrollen durchzuführen?
Ein Gespräch mit einem Experten des KLZH bringt etwas Klarheit in die Sache, auch wenn dessen wissenschaftlich differenzierte Erläuterungen hier nicht vollständig zum Ausdruck kommen können. Daniel Saurenmann (51), diplomierter Lebensmittelingenieur und Bereichsleiter Inspektorate, hält fest, dass in Zeiten der Pandemie ein paar Anbieter etwas «zu kreativ» vorgegangen seien und mit nicht geeigneter Infrastruktur gearbeitet hätten. Der Ort der Produktion, so wird deutlich, ist für die Hygiene entscheidender als die Auslieferung der Mahlzeiten. Viel könne auf dem Transportweg nicht passieren, meint Saurenmann, dazu sei das Bakterienwachstum zu langsam. Und die Transportboxen der Lieferdienste seien in der Regel «gut isoliert und hygienisch».
Wo kriminelle Energie vorhanden ist, kann dann bei der Produktion vieles im Argen liegen: Im Jahresbericht des KLZH wird der Fall eines Kebabherstellers in einem als stillgelegt gemeldeten Betrieb geschildert. Immerhin lieferte dieser illegale Betrieb 800 Kilogramm Dönerspiesse an verschiedene Abnehmer in der Umgebung, wies aber etliche Mängel bei der Rückverfolgbarkeit der Produkte, bei den baulichen Einrichtungen und bei den Gerätschaften auf.
Grundsätzlich kritischer als Lieferdienste scheinen Foodstände zu sein. Dort kann zum Beispiel die Verfügbarkeit von sauberem Wasser für das Händewaschen und das Reinigen der Geräte zum Problem werden. Man habe ab und zu «wenig anmächelige» Situationen angetroffen, erzählt Saurenmann.